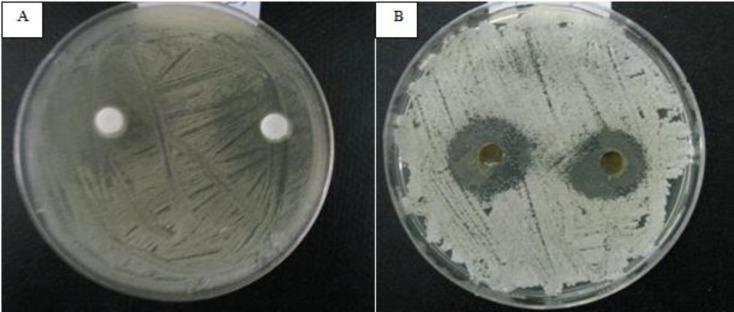

[某种植物]水醇提取物对[某些菌种]的化学成分及抗真菌作用
Chemical composition and antifungal effect of hydroalcoholic extract of against species.
作者信息
Shirani M, Samimi A, Kalantari H, Madani M, Kord Zanganeh A
机构信息
Department of Pharmacology and Toxicology, School of Pharmacy, Ahvaz Jundishapur University of Medical Sciences, Ahvaz, Iran.
Department of Microbiology, Falavarjan Branch, Islamic Azad University, Isfahan, Iran.
出版信息
Curr Med Mycol. 2017 Mar;3(1):6-12. doi: 10.18869/acadpub.cmm.3.1.6.
BACKGROUND AND PURPOSE
Treatment of life-threatening fungal infections caused by species has become a major problem. spp. are the most important causative agents of candidiasis. is a medicinal plant that has been traditionally used to treat infections. In the present study, we aimed to determine the chemical compounds and antimicrobial activity of hydroalcoholic extract of against different species of
MATERIALS AND METHODS
Phytochemical analysis was performed to identify the possible bioactive components of this extract by using gas chromatography and mass spectroscopy (GC-MS). The hydroalcoholic extract of were collected. Different concentrations of (50, 25, 12.5, and 6.25 mg/ml) were used to evaluate its antifungal activity against species ( and ) using disk diffusion assay.
RESULTS
The GC-MS analysis revealed the presence of 40 different phytoconstituents with peak area; the major compounds were tetracosane, hexadecanoic acid, 1-eicosanol, 1,2-dihydro-pyrido[3,2,1-kl]phenothiazin-3-one, 2-hexadecen-1-ol, and 3,7,11,15-tetramethyl. Hydroalcoholic extract showed strong antimicrobial activity (inhibition zone ⩾ 20 mm), moderate antimicrobial activity (inhibition zone < 12-20 mm), and no inhibition (zone < 12 mm). In addition, the hydroalcoholic extract exhibited the highest antimicrobial properties against strains.
CONCLUSION
extract had a considerable inhibitory effect against various species, but its highest inhibitory effect was against Further investigations are required to detect the performance of this plant in the treatment of infection.
背景与目的
由[具体物种]引起的危及生命的真菌感染治疗已成为一个主要问题。[具体念珠菌属物种]是念珠菌病最重要的病原体。[植物名称]是一种传统上用于治疗感染的药用植物。在本研究中,我们旨在确定[植物名称]水醇提取物对不同[具体真菌物种]的化学成分和抗菌活性。
材料与方法
采用气相色谱和质谱联用(GC-MS)对该提取物进行植物化学分析,以鉴定可能的生物活性成分。收集[植物名称]的水醇提取物。使用不同浓度的提取物(50、25、12.5和6.25mg/ml),通过纸片扩散法评估其对[具体真菌物种]([具体真菌物种1]和[具体真菌物种2])的抗真菌活性。
结果
GC-MS分析显示存在40种不同的植物成分,其峰面积各异;主要化合物为二十四烷、十六烷酸、1-二十醇、1,2-二氢吡啶并[3,2,1-kl]吩噻嗪-3-酮、2-十六碳烯-1-醇和3,7,11,15-四甲基。水醇提取物表现出强抗菌活性(抑菌圈⩾20mm)、中度抗菌活性(抑菌圈<12 - 20mm)和无抑菌作用(抑菌圈<12mm)。此外,水醇提取物对[具体真菌菌株]表现出最高的抗菌性能。
结论
[植物名称]提取物对各种[具体真菌物种]具有相当大的抑制作用,但其最高抑制作用针对[具体真菌物种]。需要进一步研究以检测该植物在治疗[具体真菌感染]中的性能。